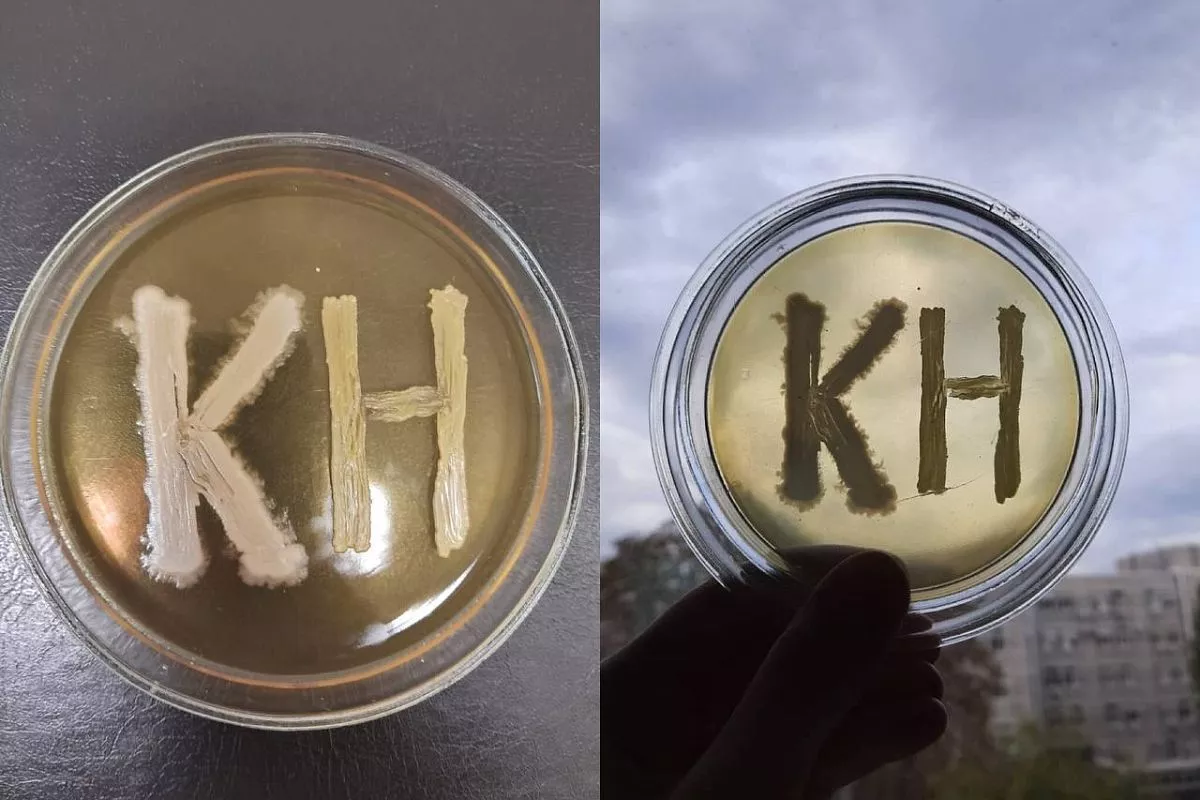
Биологотип «КН»

Студенты и преподаватели работают с микроорганизмами, чтобы сделать науку частью искусства.
Инструментов для написания картин множество. Современный зритель видел полотна, написанные маслом, кофе и даже губной помадой. Но видел ли он произведения биологов, созданные в соавторстве с бактериями?
Да-да, специалисты выращивают микроорганизмы не только в академических целях. Ведь некоторые из них предназначены для того, чтобы стать частью искусства. Об этом нам рассказала преподаватель кафедры генетики, микробиологии и биохимии КубГУ Елена Моисеева.
Бактериография как одно из направлений био-арта – зародилась в стенах вуза около десяти лет назад. Началось оно с визуальных экспериментов по «бактериальной живописи» студентов под руководством доцента Никиты Волченко. Но с приходом молодых педагогов Елены Моисеевой и Марии Кругловой и при поддержке заведующего кафедрой Александра Худокормова направление получило новый мощный толчок, стало одним из самых любимых увлечений среди студентов биофака и, что уж тут скрывать, самих преподавателей. Они с удовольствием перевоплощаются из ученых в белых халатах в художников.
Правда, вместо красок специалисты используют бактерии, а вместо полотен – чашки Петри. Прежде чем приступить к процессу, эксперты тщательно подготавливают все необходимое: выращивают разные виды бактерий, подготавливают питательную среду для своих «красок», рисуют фломастером эскиз на обратной стороне чашки и только после приступают к самому интересному – рисованию.
— Мы создаем свои рисунки с помощью почвенных бактерий, а также микроорганизмов, которые живут на поверхности растений и оседают с воздуха (сарцины, микрококки, стафилококки). Причем с последними работать проще – они сами попадают в чашку. А вот почвенные нужно дополнительно разводить, чтобы у них появился концентрат, и только потом применять в качестве красок, — рассказала нам Елена Моисеева.
Бактерии разных подвидов обладают разной пигментацией. Воздушные микроорганизмы отличаются ярким пигментом за счет того, что защищаются от ультрафиолета. Правда, на первом этапе их не видно совсем.
— Это как рисовать невидимыми красками. Берутся чистые культуры, которые имеют определенный пигмент (желтый, красный, розовый, оранжевый). Есть различные цвета, но также есть и ограничения в цветовой палитре. Потому что микроорганизмы не всегда растут таким цветом, каким хотелось бы. Только через сутки в термостате бактерии прорастают, через двое – у них начинает проявляться пигмент. Также важно учитывать, что бактерии делятся не только по цветам, но и по жизненному циклу. Пока одни растут, другие умирают, – отметила специалист.
Мир в чашках Петри уникальный и разнообразный. Никогда не знаешь, какой рисунок в итоге получится. В этом плане биологам создавать свои шедевры сложнее, чем художникам. Хотя бы потому, что их краски умеют бегать.
— Бактерии не сидят на месте и чаще всего растут хаотично. Мы помещаем их в мясопептонный агар – питательный субстрат, который они постепенно поглощают в качестве пищи. Причем делают это они в течение нескольких часов или суток. После перемещаются туда, где для них еще осталось что-нибудь “вкусное”, — добавила Елена Моисеева.
Благодаря этому процессу нарисованная картинка становится динамичной. И буквально в течение месяца-полутора умирает. Жизнь бактерий зависит от питательной среды, в которой они существуют. После того как питательные вещества микроорганизмами съедены или агар потеряет свою влажность, бактерии засыхают и цикл развития микробной картины прекращается.
У преподавателей биофака КубГУ сохранилось множество фотографий с рисунками студентов. Ребята создали с помощью бактерий композиции из цветов, котиков, мультяшных персонажей, а кому-то и вовсе удалось изобразить в маленькой чашечке знаменитогогероя сказки Сент-Экзюпери.
— Свои работы студенты выставляют на ежегодный конкурс, который проводится в стенах университета. Жюри выбирают лучшую из них, ориентируясь не только на композицию, но еще и на чистоту посева бактерий, а также использование в своей работе нескольких видов культур. После мы создаем календарь с фотографиями работ участников конкурса. В нем же публикуем сводку событий из мира микробиологии, — поделилась с нами Елена Моисеева.

А в 2021 году в рамках Года науки и технологий в Кубанском госуниверситете был дан старт ещё одной инициативе – «Science Art: Biogallery», где бактериография заняла своё достойное место. Совместный проект художественно-графического и биологического факультетов был направлен на создание биоарт-объектов из растений, животных, микроорганизмов. Произведения студентов и преподавателей биологического факультета при поддержке декана Михаила Нагалевского и руководства Кубанского госуниверситета – заняли достойные места на итоговой выставке, а также экспонировались в Краснодарском краевом художественном музее им. Ф.А. Коваленко.
В коллекции рисунков бактериями теперь есть и логотип «Кубанских новостей». Его нарисовали специалисты в соавторстве с микроорганизмами. На место в конкурсе он, конечно, претендовать не станет, в календаре – и подавно. Но зато теперь даже бактерии узнают о существовании нашей газеты. Обещали даже подписку оформить, чтобы прочитать статью о себе в спецвыпуске «Наука и точка».